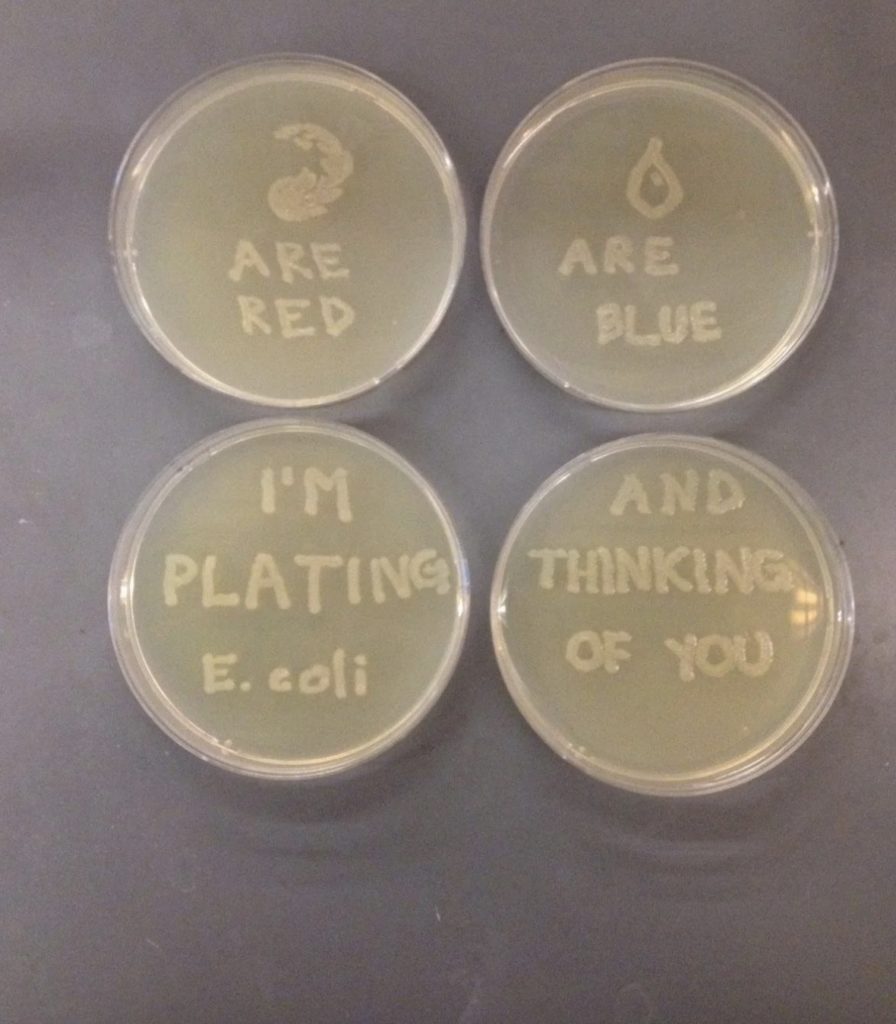

Valentine’s Day
My Lego Valentine
“Fourth grade me was shocked a Lego Valentine’s Day box at school didn’t get you all the girls.”
(via source)
Anti-Valentine’s Day
“My son was asked to decorate a paper plate at school to hold Valentines. Being that he hates Valentine’s Day, this is what they got.”
(submitted by Michele)
Card Shark
“My dad accidentally bought a same sex Valentine’s Day card and instead of getting another card, he drew a little beard on one of the women.”
(via source)
When A Man Loves A Microbiologist
“My girlfriend is a microbiologist. She just sent me this Valentine.”
(via source)
Be Our Valentine
“We took a similar photo for his Mom in 1985 when he was 1 year-old (not included here). Young man was a good sport with his dad.”
(submitted by Joe)